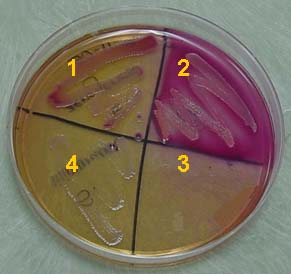

MacConkey Agar
MacConkey agar is both selective and differential. It contains bile salts and the dye crystal violet, which inhibit the growth of gram-positive bacteria and select for gram-negative bacteria. It also contains the carbohydrate lactose, which allows differentiation of gram-negative bacteria based on their ability to ferment lactose. Organisms which ferment lactose produce acid end-products which react with the pH indicator neutral red, and produce a pink color.
Quadrant 1: Growth on the plate indicates the organism, Enterobacter aerogenes, is not inhibited by bile salts and crystal violet and is a gram-negative bacterium. The pink color of the bacterial growth indicates E. aerogenes is able to ferment lactose.
Quadrant 2: Growth on the plate indicates the organism, Escherichia coli, is not inhibited by bile salts and crystal violet and is a gram-negative bacterium. The pink color of the bacterial growth indicates E. coli is able to ferment lactose.
Quadrant 3: Absence of growth indicates the organism, Staphylococcus epidermidis, is inhibited by bile salts and crystal violet and is a gram-positive bacterium.
Quadrant 4: Growth on the plate indicates the organism, Salmonella typhimurium, is not inhibited by bile salts and crystal violet and is a gram-negative bacterium. The absence of color in the bacterial growth indicates S. typhimurium is unable to ferment lactose.